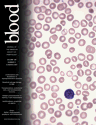
Blood Cover Image for Volume 109, Issue 6

Abstract
Adoptive transfer of T lymphocytes is a promising treatment for a variety of malignancies but often not feasible due to difficulties generating T cells that are reactive with the targeted antigen from patients. To facilitate rapid generation of cells for therapy, T cells can be programmed with genes encoding the α and β chains of an antigen-specific T-cell receptor (TCR). However, such exogenous α and β chains can potentially assemble as pairs not only with each other but also with endogenous TCR α and β chains, thereby generating αβTCR pairs of unknown specificity as well as reducing the number of exogenous matched αβTCR pairs at the cell surface. We demonstrate that introducing cysteines into the constant region of the α and β chains can promote preferential pairing with each other, increase total surface expression of the introduced TCR chains, and reduce mismatching with endogenous TCR chains. This approach should improve both the efficacy and safety of ongoing efforts to use TCR transfer as a strategy to generate tumor-reactive T cells.
Introduction
The application of molecular technologies to identify proteins differentially expressed by transformed cells is providing large numbers of candidate antigens that can be potentially targeted to selectively eliminate tumor cells by cancer immunotherapy.1,2 Efforts to vaccinate patients to such antigens have yielded some provocative results, but only a small subset of patients have demonstrated therapeutic responses, likely reflecting the many in vivo obstacles to generating potent responses to these proteins, particularly in patients with an established malignancy.3 An alternative approach of isolating and expanding reactive T cells ex vivo followed by adoptive transfer into the patient circumvents many of these in vivo obstacles. Although this adoptive therapy approach has demonstrated significant clinical promise,4 generating the large numbers of T cells required for adoptive therapy of cancer patients, particularly within the time constraints posed by progressive tumors, is often not feasible. Molecular technologies have now provided a means to more broadly capture the therapeutic potential of this treatment strategy. Genes encoding the α and β chains of a T-cell receptor (TCR) can be isolated from a T cell reactive with the antigen of interest and restricted to a defined HLA allele, inserted into a shuttle expression vector, and then introduced into large numbers of T cells of individual patients sharing the restricting allele and the targeted protein.5 This approach is already being pursued clinically,6 and the goal is to establish a library of such defined TCR genes that could provide reagents for treating a diverse set of patients and diseases. Multiple virus- and tumor-reactive TCR genes have already been successfully isolated and re-expressed in T cells, including TCR genes with specificity for HLA*0201 (HLA-A2)–restricted epitopes from melanoma antigens7–9 and HLA-A2– and HLA*2402-restricted WT1-derived epitopes.10,11
The avidity of a T cell for its target reflects many factors, including the affinity of the TCR for its cognate antigen12 and the level of TCR expression.13–15 One difficulty with the TCR-transfer approach is that the TCR-transduced T cells are often of lower avidity than the parental T cell from which the TCR was derived due to failure to achieve wild-type levels of TCR expression, which likely contributed to the limited efficacy observed in the recently reported clinical trial pursuing this strategy.6 Thus, the TCR chains introduced into T cells need to be initially selected for appropriate affinity10,16 and inserted into vectors that can achieve and maintain high-level expression.17 However, even if these criteria are met, the introduced exogenous α and β chains can potentially assemble as pairs not only with each other but also with the endogenous TCR α and β chains, thereby reducing the number of appropriately matched exogenous αβTCR pairs at the cell surface and decreasing the achievable T-cell avidity. Such mismatched pairing poses a second substantive problem for clinically pursuing this strategy: the generation of novel αβTCR pairs of undefined and potentially self-reactive specificity, as these TCRs have not been subjected to the normal rigors of negative selection. Mismatched pairing of αβTCR chains has been clearly demonstrated to occur in TCR double-transgenic mice,18 in which all 4 of the expressed TCR chains are known and can be followed. Since export of TCR chains to the cell surface only occurs after formation of complementary α and β subunits,19 the potential for pairing of introduced TCR chains with endogenous TCR chains has also been demonstrated by introducing only single α or β TCR chains into murine20 and human14 T cells and detecting expression of the introduced chain on the cell surface.
To promote preferential pairing of introduced TCR chains with each other, several strategies might be pursued. Recently, we (Stanislawski et al21 and Voss et al22 ) and others (Cohen et al23 ) have been using murine constant TCR-chain domains to enhance expression of human TCR chains in human T cells. However, murine constant domains might be immunogeneic in patients, thereby limiting the survival of transgene-transduced T cells in patients.24 As the intracellular TCR-chain domains are relatively short and do not have a signaling function, these domains on each chain could potentially be replaced by or attached to zipper domains that promote interchain recognition and binding. This strategy has proven useful for producing soluble αβTCR chains, although the utility for TCR transfer and adoptive therapy would depend on the zipper region not being immunogenic and not interfering with assembly of the full TCR complex.25 Alternatively, interactions between the extracellular domains, which can contribute to the formation of individual TCR dimers and CD3 complexes,26,27 might be modified to facilitate interchain attraction. The interactions between exogenous domains of the TCR α and β chains are generally very weak,28 and the unique naturally occurring interchain disulfide bond that occurs between the constant TCR α and β chains does not appear to contribute significantly to heterodimer stability.29 However, disulfide bonds engineered in other sites in the extracellular constant domain of the TCR αβ heterodimer may have the potential to increase interchain affinity, as suggested by such disulfide bonds enhancing formation of soluble TCR heterodimers.30–32
We sought to determine if a disulfide bond previously shown to stabilize soluble TCR heterodimers that would require only single point mutations in the constant regions of the α and β chains producing complementary cysteines could also improve matched TCR assembly when exogenous TCR chains are introduced into primary human T cells. Using a cloned TCR specific for WT1, a candidate human tumor antigen,33 we found that such point mutations both promoted preferential pairing and increased expression of the introduced chains, resulting in greater avidity of the transduced primary CD8+ T cells for WT1-expressing targets.
Materials and methods
Peptides, antibodies, multimeric complexes, and cytokines
Peptides p53264-272 and WT1126-134 were synthesized by SynPep (Dublin, CA). Antihuman CD8-FITC/PerCP/PCY5, anti–human Vβ21-FITC, anti–human Vβ13-FITC, anti–human αβTCR-PE (Beckman Coulter, Fullerton CA); anti-IFNγ–APC, annexin V–PE (BD Pharmingen, San Diego, CA); CFSE (Molecular Probes, Eugene, OR); and anti-HA and anti–mouse IgG-PE (Sigma-Aldrich, St Louis, MO) were commercially obtained. PE- or APC-labeled WT1126-134 multimeric HLA-A2 complexes (WT1126-134 multimer-PE) were synthesized as described34 or purchased (Proimmune, Springfield, VA). IFNγ enzyme-linked immunospot (ELISPOT) was performed with 1D1K and 7B61 capture and detection antibodies (Mabtech, Mariemont, OH). IL-2 was obtained from Chiron (Emeryville, CA), IL-7 from R&D Systems (Minneapolis, MN), and αCD3 (OKT3, Muromonab) from Ortho-Biotec (Bridgewater, NJ).
T-cell clones and cell lines
The generation of WT1126-134-specific CD8+ T-cell clones RS28 and CE10 has been described.35 The TAP-deficient HLA-A2–positive cell line T2 and retroviral packaging lines 293T and Phoenix-Ampho were obtained from the ATCC (Manassas, VA). Fresh leukemia samples from patients with acute myeloid leukemia (AML1 and AML2) were a kind gift of Matthias Theobald (University of Mainz, Germany).
Cloning of TCR genes and transduction, selection, and expansion of human T cells
The TCR chains expressed by CE10 and RS28 were amplified using a SMART RACE cDNA Amplification Kit (Clontech no. K1811-1; Palo Alto, CA) and sequenced. Full-length wild-type (wt) TCR αβ coding sequences were inserted into the retroviral vector pBullet (kindly provided by Ralf Willemsen).8 The TCR α and β chain inserts were modified by attaching IRES-puro and -neo cassettes (BD Pharmingen) downstream of the coding regions, respectively.16,36 The vα21wt and vβ21wt TCR chains were modified by mutagenesis of residue 48 in the Cα region from Thr to Cys and residue 57 of the Cβ region from Ser to Cys with a Quick-change XL site-directed mutagenesis kit (Stratagene, La Jolla, CA). The vα21wt and vα21Cys chains were N-terminally HA-tagged by polymerase chain reaction (PCR; denoted as vα21TAG).
Cocultured packaging cells 293T and Phoenix-Ampho were transfected using Fugene transfection reagent (Takara, Gennevilliers, France) with TCR chain (pBullet), gag-pol (pHIT60), and env (pCOLT-GALV) vectors.21 αCD3 (30 ng/mL) activated human peripheral-blood mononuclear cells (PBMCs) were transduced twice within 48 hours in the presence of 40 to 100 IU/mL IL-2 and 4 μg/mL polybrene (Sigma-Aldrich) with packaging-cell supernatant containing retroviral vectors with α or β TCR chains, GFP-IRES-neo, or IRES-neo and IRES-puro vectors. Transduced T cells were expanded by weekly stimulation with anti–human CD3/CD28 Dynabeads (1 μL/106 cells; Dynal, Oslo, Norway) and recombinant human IL-2 (rhIL-2; 40-100 IU/mL) and selected with 800 μg/mL geneticin (Gibco, Karlsruhe, Germany) and 5 μg/mL puromycin (Sigma-Aldrich) for 1 week. Polyclonal CD8+ T cells transduced with αβ chains were sorted based on level of TCR-chain surface expression and expanded in vitro using the rapid expansion protocol (REP) as described.37
Reverse transcriptase–PCR (RT-PCR), flow cytometry, and T-cell assays
Expression of introduced α and β TCR chains was quantified by real-time PCR (TaqMan) using primers with specificity for the CDR3 region (Document S1, available on the Blood website; see the Supplemental Materials link at the top of the online article). Activation-induced TCR down-modulation after 20 hours was assessed following no treatment control or triggering with 60 ng/mL αCD3 or T2 cells pulsed with 10−5 M relevant or irrelevant peptide. Relative expression of αβTCR, CD3, and the vβ21 chain was calculated as percentage mean fluorescence intensity (MFI) of maximal MFI in control cells at the indicated time points by flow cytometry. Standard 51Cr-release,38 3H-thymidine proliferation assay,39 intracellular cytokine staining,40 and IFNγ ELISPOT assays41 were performed as reported.
Results
Introducing cysteines in the constant domains of the TCR α and β chains (Cys TCR) promotes preferential assembly of appropriately matched TCR pairs
To determine if the creation of a disulfide interchain bond, previously used to stabilize soluble TCR chains,30 might promote preferential intracellular pairing of introduced TCR chains, the wild-type (wt) TCR vα21 and vβ21 chains (denoted as vα21wt and vβ21wt) were isolated from clone CE10, which is specific for WT1126-134 and HLA-A2 restricted,35 and modified by mutagenesis of residue 48 in the Cα region from Thr→Cys and residue 57 of the Cβ region from Ser→Cys (denoted as vα21Cys and vβ21Cys, respectively). The wt and Cys-modified chains were inserted individually into retroviral pBullet vectors, with each α and β TCR chain linked via an IRES element respectively to puromycin or neomycin resistance genes.16,36 CD8+ T cells from PBMCs were activated with αCD3 and IL-2, retrovirally transduced twice by spin infection with vectors containing vα21wt and vβ21wt or vα21Cys and vβ21Cys, and selected with puromycin and neomycin for 1 week.
To assess pairing of the introduced TCR chains at the cell surface, polyclonal CD8+ T cells transduced with wt and Cys chains were separately (Figure S1) or simultaneously (Figure 1A) stained with an anti-vβ21 antibody and WT1126-134-specific multimers (expression of the vα21 chain could not be independently directly assessed because of the absence of available antibodies to this chain). All T-cell analyses were performed 10 to 14 days after stimulation. The MFI with anti-vβ21–FITC was plotted against the MFI of the simultaneously obtained WT1126-134 multimer-PE signal. Over a broad range of detected expression levels of the vβ21 chain, cells expressing the Cys-modified chain reproducibly bound more multimer than cells expressing the same level of vβ21wt (Figure 1A). This was further assessed by sorting transduced T cells based either on equivalent vβ21 surface expression or WT1126-134 multimer binding. In cells sorted for nearly equivalent levels of either low or high vβ21 surface expression, T cells transduced with either wt or Cys-modified vα21 and vβ21 chains again demonstrated differences in WT1126-134 multimer binding (low: wt 1% tet+, Cys 8% tet+; high: wt 39% tet+, Cys 72% tet+; Figure 1B). T cells transduced with either wt or Cys-modified vα21 and vβ21 chains selected alternatively for equivalent binding of the WT1126-134 multimer differed in the MFI for anti-vβ21–FITC antibody staining (vβ21wt: MFI 81; vβ21Cys: MFI 37; Figure 1C), with again less vβ21Cys than vβ21wt required for the equal multimer binding. Since repetitive differences in transduction efficiency of the wt and Cys-modified α chains could contribute to the observed differences in multimer staining, the wt and Cys-modified vα21 chains were HA tagged (vα21TAG) and T cells were transduced with the wt or Cys-modified vα21TAG chain and respective wt or Cys-modified vβ21 chain, selected for equivalent vα21 and vβ21 surface expression and WT1126-134 multimer binding assessed. For these double sorts, although only T cells expressing modest levels of the transduced vβ21 chains were able to be isolated, T cells transduced with Cys-TCR chains still bound 2.5-fold more multimer than wt-TCR–transduced T cells (wt 4%, Cys 10%; Figure 1D). These results suggest that in cells expressing equivalent amounts of both of the introduced vα21 and vβ21 chains, Cys-modified αβTCR chains were functionally assembling more frequently with each other and less frequently with the endogenous TCR chains than introduced wt αβTCR chains.
Improving matched TCR pairing by introducing cysteines in the constant domain of the αβTCR chains. (A) T cells transduced with vα21wt and vβ21wt TCR chains (○), or vα21Cys and vβ21Cys TCR chains (▵), were simultaneously stained with WT1126-134 multimer-PE and the anti-vβ21–FITC antibody. MFI of the anti-vβ21–FITC signal was plotted against the MFI of the WT1126-134 multimer-PE signal. (B) Transduced cells were sorted based on equivalent levels of low (left panel) or high (right panel) vβ21 TCR chain, (C) equivalent levels of WT1126-134 multimer binding, or (D) equivalent levels of vα21TAG TCR and vβ21 TCR; expanded; and then reanalyzed for comparative expression of vβ21 (B-D), vα21-TAG (D), and binding of the WT1126-134 multimer (B-D). (Mock-transduced T cells, thin line; wt-TCR transduced, dotted line; Cys-TCR transduced, dashed line.) (E) T cells mock transduced or transduced with vα21wt and vβ21wt TCR chains or vα21Cys and vβ21Cys TCR chains were stained for total TCR expression by an anti-αβTCR–PE antibody (MFI from 3 independent experiments were averaged; left). T cells transduced with vα21wt and vβ21wt TCR chains (▪) or vα21Cys and vβ21Cys TCR chains (□) were selected for lower (denoted as L: MFI 16) or higher (denoted as H: MFI 28) vβ21 TCR-chain expression and then were either not treated or stimulated with αCD3 (60 ng/mL) or T2 cells pulsed with irrelevant (p53264-272) or relevant (WT1126-134) 10−5M peptide. TCR-chain surface expression was calculated as percentage MFI of anti-αβTCR–PE (middle) or anti-vβ21–FITC (right) staining in the stimulated groups compared with control unstimulated cells. Error bars indicate SEM.
Improving matched TCR pairing by introducing cysteines in the constant domain of the αβTCR chains. (A) T cells transduced with vα21wt and vβ21wt TCR chains (○), or vα21Cys and vβ21Cys TCR chains (▵), were simultaneously stained with WT1126-134 multimer-PE and the anti-vβ21–FITC antibody. MFI of the anti-vβ21–FITC signal was plotted against the MFI of the WT1126-134 multimer-PE signal. (B) Transduced cells were sorted based on equivalent levels of low (left panel) or high (right panel) vβ21 TCR chain, (C) equivalent levels of WT1126-134 multimer binding, or (D) equivalent levels of vα21TAG TCR and vβ21 TCR; expanded; and then reanalyzed for comparative expression of vβ21 (B-D), vα21-TAG (D), and binding of the WT1126-134 multimer (B-D). (Mock-transduced T cells, thin line; wt-TCR transduced, dotted line; Cys-TCR transduced, dashed line.) (E) T cells mock transduced or transduced with vα21wt and vβ21wt TCR chains or vα21Cys and vβ21Cys TCR chains were stained for total TCR expression by an anti-αβTCR–PE antibody (MFI from 3 independent experiments were averaged; left). T cells transduced with vα21wt and vβ21wt TCR chains (▪) or vα21Cys and vβ21Cys TCR chains (□) were selected for lower (denoted as L: MFI 16) or higher (denoted as H: MFI 28) vβ21 TCR-chain expression and then were either not treated or stimulated with αCD3 (60 ng/mL) or T2 cells pulsed with irrelevant (p53264-272) or relevant (WT1126-134) 10−5M peptide. TCR-chain surface expression was calculated as percentage MFI of anti-αβTCR–PE (middle) or anti-vβ21–FITC (right) staining in the stimulated groups compared with control unstimulated cells. Error bars indicate SEM.
The level of vβ21 detected in transduced T cells directly correlated with the intensity of multimer staining (Figure 1A-D), implying that the goal of achieving higher levels of introduced TCR chains will in fact result in transduced T cells with higher avidity for targets. To determine if limitations on the levels of TCR that can be achieved on the cell surface existed, T cells transduced with mock, wt, or Cys-modified TCR chains were stained with an anti-αβTCR antibody. In 3 separate experiments, independent of the level of transduced chains attained, no differences in total αβTCR surface expression were found (Figure 1E left), suggesting that the total αβTCR surface expression is limited by factors other than just expression of more TCR chains, such as components of the TCR complex or adaptor proteins that affect assembly or export of TCR complexes.42,43 Thus, if TCR chains are being introduced into primary T cells, strategies that modify the chains to promote appropriate pairing and/or enhanced assembly and export have increased importance for expression of the desired TCR.
Differences in multimer binding by T cells transduced with wt and Cys-modified TCR chains expressing equivalent levels of vα21 and vβ21 suggested that Cys-modified chains were preferentially pairing, and, to assess the extent of mismatching of introduced TCR chains with endogenous TCR chains, we took advantage of the fact that the TCR is down-modulated following encounter with antigen. This event is selective since T cells engineered to express 2 sets of TCR chains with known specificity only down-modulate the TCR with specificity for the presented antigen.44 T cells transduced with wt or Cys-modified αβTCR chains were sorted for comparable vβ21 TCR-chain surface expression and stimulated with αCD3 or 10−5 M peptide, and total αβTCR and transduced vβ21 TCR surface expression was assessed 20 hours later by flow cytometry. αCD3 activation of T cells transduced with either wt or Cys-modified TCR chains resulted in a nearly complete down-modulation of αβTCR and the vβ21 TCR in T cells that had been previously selected based on lower or higher amounts of vβ21 TCR-chain surface expression (Figure 1E middle and right). In contrast, antigen-specific activation only reduced 10% of αβTCRs in T cells expressing low levels of vβ21wt and 16% when expressing higher levels but reduced 27% and 35% of all αβTCRs in T cells when transduced with lower and higher levels of vβ21Cys. Staining for vβ21 expression demonstrated that vβ21Cys chains were nearly completely down-regulated (low vβ21Cys 95%, high vβ21Cys 98%), whereas only 59% or 41% of vβ21wt was removed from the surface of cells expressing lower or higher levels of vβ21wt. The residual vβ21 TCRs, primarily detected in T cells transduced with the wt TCR chains, most likely represent vβ21 chains paired with an endogenous α chain and thus do not respond to antigen. Thus, introducing a disulfide bond into the TCR chains appeared to reduce mismatching and increase the amount of matched functional αβTCR pairs at the cell surface.
T cells with increased appropriately matched TCR pairs at the cell surface recognize target cells more efficiently
Increased expression of appropriately matched pairs of the introduced TCR chains should translate into more efficient target recognition if the receptors signal normally, since target avidity has been shown to correlate with level of TCR expression.14 Therefore, transduced T cells were sorted for comparable vβ21 TCR surface expression, equivalent amounts of α chain for wt and Cys-TCR–transduced T cells were confirmed by RT-PCR (Document S1), and T cells were analyzed for cytokine production in an INFγ ELISPOT assay using as stimulators T2 cells pulsed with titrated amounts of the WT1126-134 peptide. The frequency of T cells responding to antigen over a broad range of antigen concentrations was greater in T cells with the Cys-modified TCR chains than with the wt TCR chains, and these differences were observed in comparisons of T cells expressing either equivalent low, intermediate, or high levels of the vβ21 TCR chain (Figure 2A).
T cells with increased appropriately matched TCR pairs at the cell surface recognize target cells more efficiently. (A) T cells mock transduced (×) or transduced with vα21wt and vβ21wt TCR chains (open symbols) or vα21Cys and vβ21Cys TCR chains (closed symbols) were selected by flow cytometry for lower (vβ21: MFI 7 ▴, ▵), intermediate (vβ21: MFI 12; •, ○), or higher (vβ21: MFI 50; ▪, □) levels of expression of the introduced vβ21 chain. The cell populations were analyzed with an IFNγ ELISPOT assay at the indicated peptide concentration at an effector-target (E/T) ratio of 0.3:1. (B-C) The proliferative responses of transduced T cells selected for expressing either vα21wt vβ21wt (vβ21wt MFI 48; B, ▪; C, dotted line) or the vα21Cys vβ21Cys (vβ21Cys MFI 45; B, □; C, dashed line) to stimulation with irrelevant (p53264-272: p53) or relevant (WT1126-134: WT1) peptide-pulsed irradiated PBMCs at a responder-stimulator (R/S) ratio of 1:1 assessed by (B) 3H-thymidine incorporation (C) or CFSE staining at 4 days. Statistical analysis in panel B was performed with a t test. Error bars indicate SEM. (D) Transduced T cells selected for expression of either vβ21wt or the vβ21Cys at an MFI of 7 were analyzed for recognition of 2 different AML samples (▴, ▵ and ▾, ▿) in a 5-hour 51chromium-release assay. The assays were performed in the presence of excess (20:1) cold target T2 cells pulsed with either the relevant (open symbols, thin lines) or irrelevant peptide (closed symbols, bold lines).
T cells with increased appropriately matched TCR pairs at the cell surface recognize target cells more efficiently. (A) T cells mock transduced (×) or transduced with vα21wt and vβ21wt TCR chains (open symbols) or vα21Cys and vβ21Cys TCR chains (closed symbols) were selected by flow cytometry for lower (vβ21: MFI 7 ▴, ▵), intermediate (vβ21: MFI 12; •, ○), or higher (vβ21: MFI 50; ▪, □) levels of expression of the introduced vβ21 chain. The cell populations were analyzed with an IFNγ ELISPOT assay at the indicated peptide concentration at an effector-target (E/T) ratio of 0.3:1. (B-C) The proliferative responses of transduced T cells selected for expressing either vα21wt vβ21wt (vβ21wt MFI 48; B, ▪; C, dotted line) or the vα21Cys vβ21Cys (vβ21Cys MFI 45; B, □; C, dashed line) to stimulation with irrelevant (p53264-272: p53) or relevant (WT1126-134: WT1) peptide-pulsed irradiated PBMCs at a responder-stimulator (R/S) ratio of 1:1 assessed by (B) 3H-thymidine incorporation (C) or CFSE staining at 4 days. Statistical analysis in panel B was performed with a t test. Error bars indicate SEM. (D) Transduced T cells selected for expression of either vβ21wt or the vβ21Cys at an MFI of 7 were analyzed for recognition of 2 different AML samples (▴, ▵ and ▾, ▿) in a 5-hour 51chromium-release assay. The assays were performed in the presence of excess (20:1) cold target T2 cells pulsed with either the relevant (open symbols, thin lines) or irrelevant peptide (closed symbols, bold lines).
The ability of gene-modified T cells to survive and proliferate in response to target recognition will likely contribute to therapeutic efficacy. To assess survival of T cells transduced with wt and Cys TCRs following antigen-specific stimulation, transduced T cells were selected for equivalent levels of vβ21 expressions by flow cytometry and stimulated with WT1126-134-pulsed PBMCs, and activation-induced cell death (AICD) was assessed after stimulation by annexin V staining 4 days later. At 4 days, approximately 20% of cells from cultures of both wt and Cys-TCR–transduced T cells were annexin V+ (data not shown). Proliferation was also assessed 4 days after stimulation by both 3H-thymidine incorporation and CFSE dilution. After stimulation with the WT1126-134 peptide, a larger fraction of T cells transduced with Cys-modified TCR chains entered cycle and proliferated more extensively than T cells with wt TCR chains (Figure 2B-C), and enumeration revealed 2.1-fold more cells present at day 4.
The failure of T cells expressing low levels of an introduced TCR to effectively eliminate cancer cells has been further suggested by the results of a recent clinical trial employing TCR gene-transfer technology.6 To test whether observed differences in avidity between wt- and Cys-TCR–transduced T cells could translate to improved recognition of leukemic blasts in T cells expressing only low levels of introduced TCR chains, T cells transduced with wt or Cys-modified TCR chains were selected for equivalent vβ21 surface expression at an MFI of 7. Two different leukemic blast samples isolated from HLA-A2+ AML patients demonstrated by RT-PCR to overexpress WT1 were used as targets in a 5-hour 51Cr release assay. The specificity of the observed lysis for the WT1126-135 antigen of leukemia cells was assessed by including as cold target inhibitors T2 cells pulsed with the WT1 or an irrelevant peptide but not labeled with 51Cr. T cells transduced with Cys-modified TCR chains lysed leukemic blasts in the presence of a 20:1 excess of T2 cells loaded with an irrelevant HLA-A–restricted peptide, whereas T cells transduced with the wt TCR chains lacked sufficient avidity to lyse these leukemic targets (Figure 2D). Addition of “cold” T2 target cells pulsed with the WT1 epitope inhibited lysis of the leukemia cells by T cells transduced with Cys-modified TCR chains, affirming the specificity of the lytic activity in these cells despite low levels of the TCR chains and demonstrating that the leukemic cells processed and presented the WT1126-134 epitope (Figure 2D).
Transcription, translation, and expression of wt and Cys-modified TCR chains
The Cys modifications of the TCR chains, which promoted preferential pairing, might also influence expression of the modified chains by modifying protein production, stability, or complex assembly. Therefore, T cells transduced with mock, wt, or Cys-modified TCR chains were stained for surface expression of vβ21 TCR chain following drug selection with puromycin and neomycin. After each set of transductions, the parental T-cell clone was analyzed for comparison and always had the highest surface expression of the vβ21 TCR chain (MFI 32). In 7 independent experiments, despite the use of identical expression vectors, promoters, and selection procedures for both the wt and Cys-modified TCR chains, surface expression of the vβ21Cys TCR chain (MFI 24) was reproducibly significantly higher than expression of the vβ21wt TCR chain (MFI 15; Figure 3A; Figures S1-2), suggesting that the Cys modification might be providing an additional benefit for expression beyond just preferential pairing.
Transcription, translation, and expression of wt and Cys-modified TCR chains. (A) The T-cell clone CE10 (bold line), human mock-transduced T cells (thin line), and T cells transduced with the vα21wt and vβ21wt (dotted line) or vα21Cys and vβ21Cys TCR chains (dashed line) were stained with an anti-vβ21–FITC antibody. (B) Vα21 and vβ21 chain RNA from T cells transduced with the vα21wt and vβ21wt or vα21Cys and vβ21Cys TCR chains was quantitated by TaqMan RT-PCR and normalized to β-actin message. Error bars indicate SEM. (C) Mock-transduced T cells (thin line) and clone CE10 (bold line) were treated with paraformaldehyde and stained with the anti-vβ21–FITC antibody. (D) The T-cell clone CE10 (bold line), mock-transduced T cells (thin line), and T cells transduced with vα21wt and vβ21wt (dotted line) or vα21Cys and vβ21Cys TCR chains (dashed line) were treated with paraformaldehyde, permeabilized, and stained with the anti-vβ21–FITC antibody.
Transcription, translation, and expression of wt and Cys-modified TCR chains. (A) The T-cell clone CE10 (bold line), human mock-transduced T cells (thin line), and T cells transduced with the vα21wt and vβ21wt (dotted line) or vα21Cys and vβ21Cys TCR chains (dashed line) were stained with an anti-vβ21–FITC antibody. (B) Vα21 and vβ21 chain RNA from T cells transduced with the vα21wt and vβ21wt or vα21Cys and vβ21Cys TCR chains was quantitated by TaqMan RT-PCR and normalized to β-actin message. Error bars indicate SEM. (C) Mock-transduced T cells (thin line) and clone CE10 (bold line) were treated with paraformaldehyde and stained with the anti-vβ21–FITC antibody. (D) The T-cell clone CE10 (bold line), mock-transduced T cells (thin line), and T cells transduced with vα21wt and vβ21wt (dotted line) or vα21Cys and vβ21Cys TCR chains (dashed line) were treated with paraformaldehyde, permeabilized, and stained with the anti-vβ21–FITC antibody.
It was possible that this increased surface expression might have merely reflected increased integration of retroviral vector copies in these experiments with subsequent augmented RNA levels. Therefore, RNA was isolated from T cells transduced with wt or Cys-modified TCR chains, and the vβ21 chain message was quantitated by RT-PCR and normalized to β-actin copies. No difference in vα21 or vβ21 RNA expression was observed on T cells transduced with wt or Cys-modified TCR chains (Figure 3B), suggesting equivalent levels of transcription of the wt and modified genes.
Increased translation of transcripts from the point-mutated gene could also lead to augmented vβ21 Cys expression. Therefore, intracellular vβ21 TCR protein levels were assessed by flow cytometry. To permit analysis of intracellular and not surface TCR chains in single cells, cells were fixed with paraformaldehyde to mask antibody-binding sites and inhibit binding to the cell surface and then permeabilized. The efficiency of masking the binding site for the anti-vβ21 antibody on surface molecules by paraformaldehyde was assessed by incubating the parental T-cell clone CE10 with the anti-vβ21–FITC antibody in the presence or absence of paraformaldehyde, with or without saponin permeabilization. Paraformaldehyde completely blocked anti-vβ21–FITC surface binding, but intracellular vβ21 remained detectable after permeabilization with saponin (Figure 3C-D). Intracellular vβ21 protein levels in the parental clone were highest (MFI 21), but, in contrast to the differences in surface expression of wt or Cys-modified vβ21, intracellular vβ21 in T cells transduced with wt or Cys-modified TCR chains were almost identical (both MFI 18; Figure 3D) and nearly equivalent to the parental clone. Thus, the higher levels of Cys-modified TCR chains detected on the surface did not appear to reflect enhanced transcription or translation, suggesting that exogenous TCR α and β chains modified with paired cysteines may be more favorably assembled and exported as TCR complexes.
Increased surface expression of Cys-modified TCR chains is not unique to a single TCR αβ pair but does require corresponding cysteines be present on both TCR α and β chains
To determine if the increased surface expression of Cys-modified TCR chains only reflected a unique property of chains from clone CE10, the same Cys modifications were introduced into TCR chains isolated from clone RS28, which is also specific for WT1126-134 but employs different αβ chains. T cells transduced with either wt- or Cys-modified vα4 and vβ13 TCR chains were selected by resistance to antibiotics and stained for vβ13 TCR surface expression. As previously observed with vα21 and vβ21 TCR chains (Figure 3A), T cells transduced with Cys-modified TCR chains from RS28 exhibited enhanced vβ surface expression (the α chain of this TCR, vα4, again could not be directly stained) compared with cells transduced with wt chains (Figure 4A).
Increased surface expression of Cys-modified TCR chains is not unique to a single TCR αβ pair and requires presence of a corresponding cysteine on both chains. (A) Mock-transduced T cells (thin line) and T cells transduced with vα4wt and vβ13wt (dotted line) or vα4Cys and vβ13Cys TCR chains (dashed line) were stained with anti-vβ13–FITC antibody. (B) Mock-transduced T cells (thin line) and T cells transduced with vα21wt and vβ13wt (dotted line) or vα21Cys and vβ13Cys TCR chains (dashed line) were stained with anti-vβ13–FITC antibody. (C) Mock-transduced T cells (thin line) and T cells transduced with vα4wt and vβ13wt (thick line) or vα4wt and vβ13Cys TCR chains (dashed line) were stained with anti-vβ13–FITC antibody. (D) Mock-transduced T cells (thin line) and T cells transduced with vα21wt and vβ21wt (thick line) or vα21wt and vβ21Cys TCR chains (dashed line) were stained with anti-vβ21–FITC antibody. (E) Mock-transduced T cells (thin line) and T cells transduced with vα21wt and vβ21wt (thick line), vβ21wt TCR chain alone (dotted line), or vβ21Cys TCR chain alone (dashed line) were stained with anti-vβ21–FITC antibody. (F) Mock-transduced T cells (thin line) and T cells transduced with vα21TAGwt and vβ21wt (thick line), vα21TAGwt TCR chain alone (dotted line), or vα21TAGCys TCR chain alone (dashed line) were stained with anti-TAG–PE antibody. All results are representative of a least 3 independent experiments.
Increased surface expression of Cys-modified TCR chains is not unique to a single TCR αβ pair and requires presence of a corresponding cysteine on both chains. (A) Mock-transduced T cells (thin line) and T cells transduced with vα4wt and vβ13wt (dotted line) or vα4Cys and vβ13Cys TCR chains (dashed line) were stained with anti-vβ13–FITC antibody. (B) Mock-transduced T cells (thin line) and T cells transduced with vα21wt and vβ13wt (dotted line) or vα21Cys and vβ13Cys TCR chains (dashed line) were stained with anti-vβ13–FITC antibody. (C) Mock-transduced T cells (thin line) and T cells transduced with vα4wt and vβ13wt (thick line) or vα4wt and vβ13Cys TCR chains (dashed line) were stained with anti-vβ13–FITC antibody. (D) Mock-transduced T cells (thin line) and T cells transduced with vα21wt and vβ21wt (thick line) or vα21wt and vβ21Cys TCR chains (dashed line) were stained with anti-vβ21–FITC antibody. (E) Mock-transduced T cells (thin line) and T cells transduced with vα21wt and vβ21wt (thick line), vβ21wt TCR chain alone (dotted line), or vβ21Cys TCR chain alone (dashed line) were stained with anti-vβ21–FITC antibody. (F) Mock-transduced T cells (thin line) and T cells transduced with vα21TAGwt and vβ21wt (thick line), vα21TAGwt TCR chain alone (dotted line), or vα21TAGCys TCR chain alone (dashed line) were stained with anti-TAG–PE antibody. All results are representative of a least 3 independent experiments.
To determine if the effect of Cys modifications on expression would occur even if the TCR chains were not selected based on natural pairing, T cells were transduced with either the wt or Cys-modified α chain of clone CE10 (vα21) and the wt or Cys-modified β chain of clone RS28 (vβ13). T cells expressing such unrelated TCR chains predictably did not acquire specificity for WT1126-134 (data not shown). However, as observed for T cells transduced with the α and β chains from clone CE10 (Figure 3A) or RS28 (Figure 4A), transduction with the combination of the α chain from clone CE10 (vα21) and the β chain from clone RS28 (vβ13) led to more efficient expression if both chains were Cys modified (Figure 4B), demonstrating the effect of the Cys mutations on expression was independent of the specificity of paired variable TCR domains.
To determine the effect of having the Cys modification on only 1 chain, T cells were transduced with combinations of vαwt/vβwt or vαwt/vβCys chains from clone RS28 or CE10. In contrast to the observed increased surface expression of Cys-modified β chains from both clones when the cysteine was also present on the introduced α chain, vβCys chain surface expression was actually reduced compared with the vβwt chain when the corresponding cysteine was not present in an α chain (Figure 4C-D).
The reduced expression of a Cys-modified β chain when expressed in combination with an introduced wt α chain in T cells suggested that Cys-modified TCR chains might also be less capable of efficiently pairing with endogenous wt TCR chains that lack Cys modifications. To assess surface expression and thus pairing of Cys-modified β chain selectively with endogenous α TCR chains, T cells were transduced with wt or Cys-modified vβ21 alone or vβ21wt with or without vα21wt and stained with anti-vβ21 antibody. T cells transduced with vβ21wt alone or a combination of vα21wt and vβ21wt expressed vβ21 at equivalent levels. In contrast, cells transduced with vβ21Cys alone expressed much lower levels at the cell surface (Figure 4E). To assess whether a Cys-modified α chain would pair less efficiently with endogenous β TCR chains, T cells were transduced with wt or Cys-modified vα21TAG alone or vα21TAGwt with or without vβ21wt and stained with an anti-TAG–PE antibody. As observed for vβ21Cys, vα21TAGCys was less efficiently expressed at the cell surface compared with the wt chain either with or without its matched β chain (Figure 4F). Thus, both Cys-modified vα21 and vβ21 chains pair less efficiently with endogenous wt chains.
Discussion
The introduction of an additional set of α and β TCR chains into a T cell creates a situation in which the cell can express 4 different TCR pairs: the natural endogenous and introduced exogenous TCRs and 2 additional TCRs formed by mismatched pairing of the introduced α and β TCR chains with the endogenous β and α TCR chains, respectively. Such mismatched pairing poses potentially substantive problems for the use of TCR transfer as a clinical strategy, since the specificity of the mismatched pairs will be unknown and potentially autoreactive. In the absence of any preferential pairing of the 2 introduced chains with each other or between the 2 endogenous TCR chains, only 50% of introduced TCR chains would be predicted to be paired with each other. Although recent reports have demonstrated that preferential pairing can occur between selected α and β TCR chains,45 such events appear relatively rare and not sufficiently predictable to readily permit selection of TCR chains for use in TCR transfer that have unique naturally high affinities for each other.46 Using antigen-specific down-modulation of the introduced β TCR chain derived from the WT1-specific clone CE10 to reflect incorporation into matched versus mismatched pairs, our data demonstrated that, depending on the level of expression of introduced TCR chains, approximately 40% to 60% of wt β chains were not down-modulated following antigen-specific stimulation in T cells expressing lower levels of introduced TCR chains. Thus, the introduced wt TCR chains did not exhibit a significant preference to assemble with each other rather than the endogenous TCR chains. However, engineering point mutations in each of the introduced chains that can promote formation of a disulfide bond between the constant ectodomains significantly altered these apparently largely random interactions between α and β chains, with approximately 95% of the TCR complexes containing the introduced Cys-modified β chain down-modulated by specific stimulation with antigen independent of the level of chain expression achieved, suggesting that the exogenous Cys-modified TCR chains were overwhelmingly pairing with each other. This might reflect the cysteine bonds promoting preferential interactions between the chains and/or increasing the conformational stability of the proteins after interacting,47 since these particular cysteine modifications have been shown to stabilize a number of soluble TCR αβ chains.30–32 This preferential pairing should improve the safety of TCR transfer, since, with this approximately 1-log reduction in expression of mismatched pairs, the avidity of T cells expressing these low levels of mismatched TCR chains even if potentially autoreactive should be greatly reduced for the relevant target.14
The insertion of these cysteines in the TCR chains appeared to have another unanticipated and beneficial activity. In particular, not only was the percent of matched TCR chains at the cell surface increased but the total amount of introduced TCR chains at the cell surface was also increased. This outcome might again reflect formation of more intrinsically stable conformations between the modified chains, providing these pairs of TCR chains with a competitive advantage for assembly and incorporation into more stabilized complete TCR-CD3 complexes that then get exported to the cell surface. Alternatively, it might reflect the cysteine modifications leading to a conformation more favorable for interacting with limiting components of the TCR-CD3 complex. The observed increase in expression of introduced chains occurred in the context of evidence that the total amount of TCR-CD3 complexes on the cell surface, composed of the sum of receptors with endogenous and exogenous chains, did not differ from nontransduced T cells, consistent with evidence that the total amount of TCR-CD3 complexes expressed on the T-cell surface on T cells is regulated and limited. Such a limit has also been observed after transfer of αβTCR chains into γδ T cells,48 presumably because other components of the TCR-CD3 complex, such as CD3ζ42 or the transmembrane adaptor protein TRIM,43 rather than the TCR chains themselves, limit assembly and export and ultimately the amount of TCR expressed. Thus the introduced TCR chains must compete with the endogenous chains for expression, and methods that provide the introduced chains with a competitive advantage would be useful. This could include using stronger promoters to induce higher expression levels of exogenous compared with endogenous TCR chains,17 thereby providing the introduced TCR chains with a numeric advantage for competition with limiting components of the CD3 complex. Alternatively, components of the TCR-CD3 complex that limit expression, such as the CD3ζ chain, could be expressed in T cells along with introduced TCR chains,8 but more than 1 component might be limiting, which could make this approach challenging. However, regardless of the mechanism engaged, strategies such as engineering a disulfide bridge between TCR chains that result in enhanced surface expression of the introduced chains should translate into approved avidity of the transduced T cells for the targeted antigen.
The observed enhanced formation of matched pairs of cysteine-modified introduced TCR chains clearly had the desired outcome of reducing formation of unwanted mismatched pairs of unknown specificity. However, the efficiency with which mismatching was avoided seemed surprising, with only approximately 5% of the introduced chains appearing to be in TCR complexes that failed to respond to antigen targeted by the TCR. This high efficiency made us question if the introduction of cysteine modifications not only enhanced the formation and export of matched pairs but also interfered with the formation of mismatched pairs. Our results support this hypothesis, as, in distinction to the higher expression observed with introduction of 2 Cys-modified chains, introduction of TCR chains in which only a single chain was Cys modified was not a neutral event but rather reproducibly resulted in decreased expression of the introduced chains. Such reduced expression of pairs of TCR chains in which 1 has a novel cysteine might reflect abnormal folding and degradation of these pairs as a consequence of formation of improper disulfide bonds with other cysteines naturally present in the other chain; indeed incorrect disulfide formation has been shown to reduce the folding capacity of TCR chains in other settings.28 Thus, Cys-modified TCR chains are not only more likely to form matched pairs but also appear less capable of forming productive pairs with chains that lack the complementary cysteine. However, cysteine modification did not appear to completely prevent pairing with endogenous TCR chains, and strategies that can further reduce mismatching would still be desirable.
In summary, our results demonstrate that introducing artificial cysteines in the constant region of the chains of a TCR has multiple beneficial effects for the strategy of imparting T-cell specificity by TCR transfer, including enhanced expression of matched pairs, reduced expression of mismatched pairs, and increased proportional expression of the introduced TCR chains in the total TCR pool. These changes result in greater avidity for target cells expressing the recognized antigen and reduced risk of producing a T cell expressing sufficient levels of an undesirable TCR formed from an unpredictable pair of an endogenous and exogenous chain to mediate autoimmune injury. Thus, this approach should improve both the efficacy and safety of the ongoing efforts to use TCR transfer as a strategy to generate T cells that can be used for therapy of malignant diseases.
Authorship
Contribution: J.K. designed, performed, and analyzed experiments. M.L.D. and W.Y.H. cloned T cells and T-cell receptors. M.W., R.-H.V., and C.F. designed and analyzed experiments. P.D.G. analyzed experiments. J.K. and P.D.G. wrote the manuscript. All authors edited and approved the written manuscript.
Conflict-of-interest disclosure: The authors declare no competing financial interests.
Correspondence: Jüurgen Kuball, Fred Hutchinson Cancer Research Center, 1100 Fairview Avenue N, Thomas Building, D3-100, Seattle, WA 98109; e-mail: jkuball@fhcrc.org; or Philip D. Greenberg, University of Washington, BB1325 Health Sciences Building, Box 356527, Seattle, WA 98195; e-mail: pgreen@u.washington.edu.
The online version of this article contains a data supplement.
The publication costs of this article were defrayed in part by page charge payment. Therefore, and solely to indicate this fact, this article is hereby marked “advertisement” in accordance with 18 USC section 1734.
This work was supported by grants from the Leukemia & Lymphoma Society (LLS 7040-03) and the National Institutes of Health (P01 CA18029, R37 CA33084). J.K. and M.W. are fellows of the Deutsche Krebshilfe (Germany) and M.L.D. was supported by a Poncin Scholarship.
We gratefully appreciate expert technical contributions by Jianhong Cao and Hieu N. Nguyen.
Current address for W.Y.H.: Genentech Inc, 1 DNA Way, MS-88, South San Francisco, CA 94080-4918.